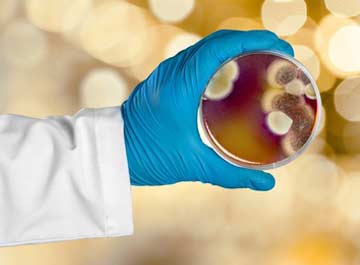
Gallery image 5 — water damage second opinion Tampa

When disaster strikes your home or business in Tampa, you need a restoration partner you can trust to act fast, do the job right, and protect your family's health. That's where NextGen Restoration comes in. As a family-owned and operated company with over 20 years of experience, we've built our reputation on being the most trusted certified master water and fire restorers in the region.
Our commitment goes beyond just fixing the visible damage. We understand that your safety and peace of mind are paramount. That's why we invest in the latest technology, like our advanced DAMP moisture detection system, to ensure hidden moisture is completely eliminated, preventing future mold growth and structural issues. Our team of nationally certified experts is available 24/7, ready to dispatch in minutes to handle any emergency, from burst pipes and roof leaks to fire and smoke damage.
We are more than just a service provider; we are your advocate. As licensed State of Florida contractors, we manage every phase of the project, from initial emergency mitigation to the final rebuild, ensuring your property is restored to its pre-loss condition. We also stand by your side with insurance billing support and provide expert consulting and second opinions. At NextGen Restoration, we're not just restoring properties; we're restoring lives.